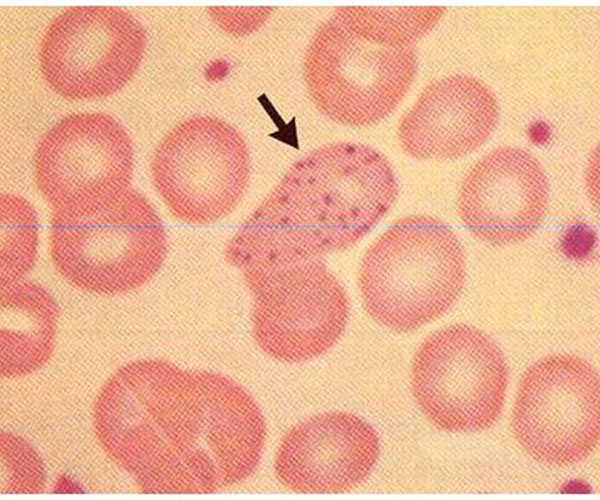

Κατά τη διάρκεια του 20ου αι. στις Η.Π.Α., όσοι υποστήριξαν το γυναικείο φύλο χρησιμοποίησαν ως επιταγή στον πολιτικό χώρο, τον ισχυρισμό της γυναικείας ηθικότητας. Η θέση αυτή συμπεριλάμβανε ένα ευρύ φάσμα αντιλήψεων που σχετίζονταν με την αξία της μητρικής στοργής και αγάπης, της διατήρησης των δεσμών των κοινωνικών υποκειμένων με το θεμελιώδες αγαθό της ειρηνικής συνύπαρξης των ατόμων. Παρ’ όλη την επιμονή των υπέρμαχων του γυναικείου φύλου, η προσέγγιση αυτή αποδείχθηκε ατελέσφορη, καθώς στις Η.Π.Α. οι γυναίκες αντιμετωπίζονταν ως ανεπιθύμητες στην πολιτική, πολιτισμική και οικονομική σφαίρα δράσης. Πηγή:http://www.deviantart.com/ Η συγγραφέας αντ’ αυτού, προτείνει τον επαναπροσδιορισμό του εξουσιαστικού συστήματος όπως και των δικαιωμάτων της πολιτείας σε μία κοινωνία που θα επικρατούν δικαιϊκές πεποιθήσεις, στηριγμένες στη γυναικεία ευαισθητοποίηση και στην «παραδοσιακή γυναικεία ηθικότητα», δηλαδή ...